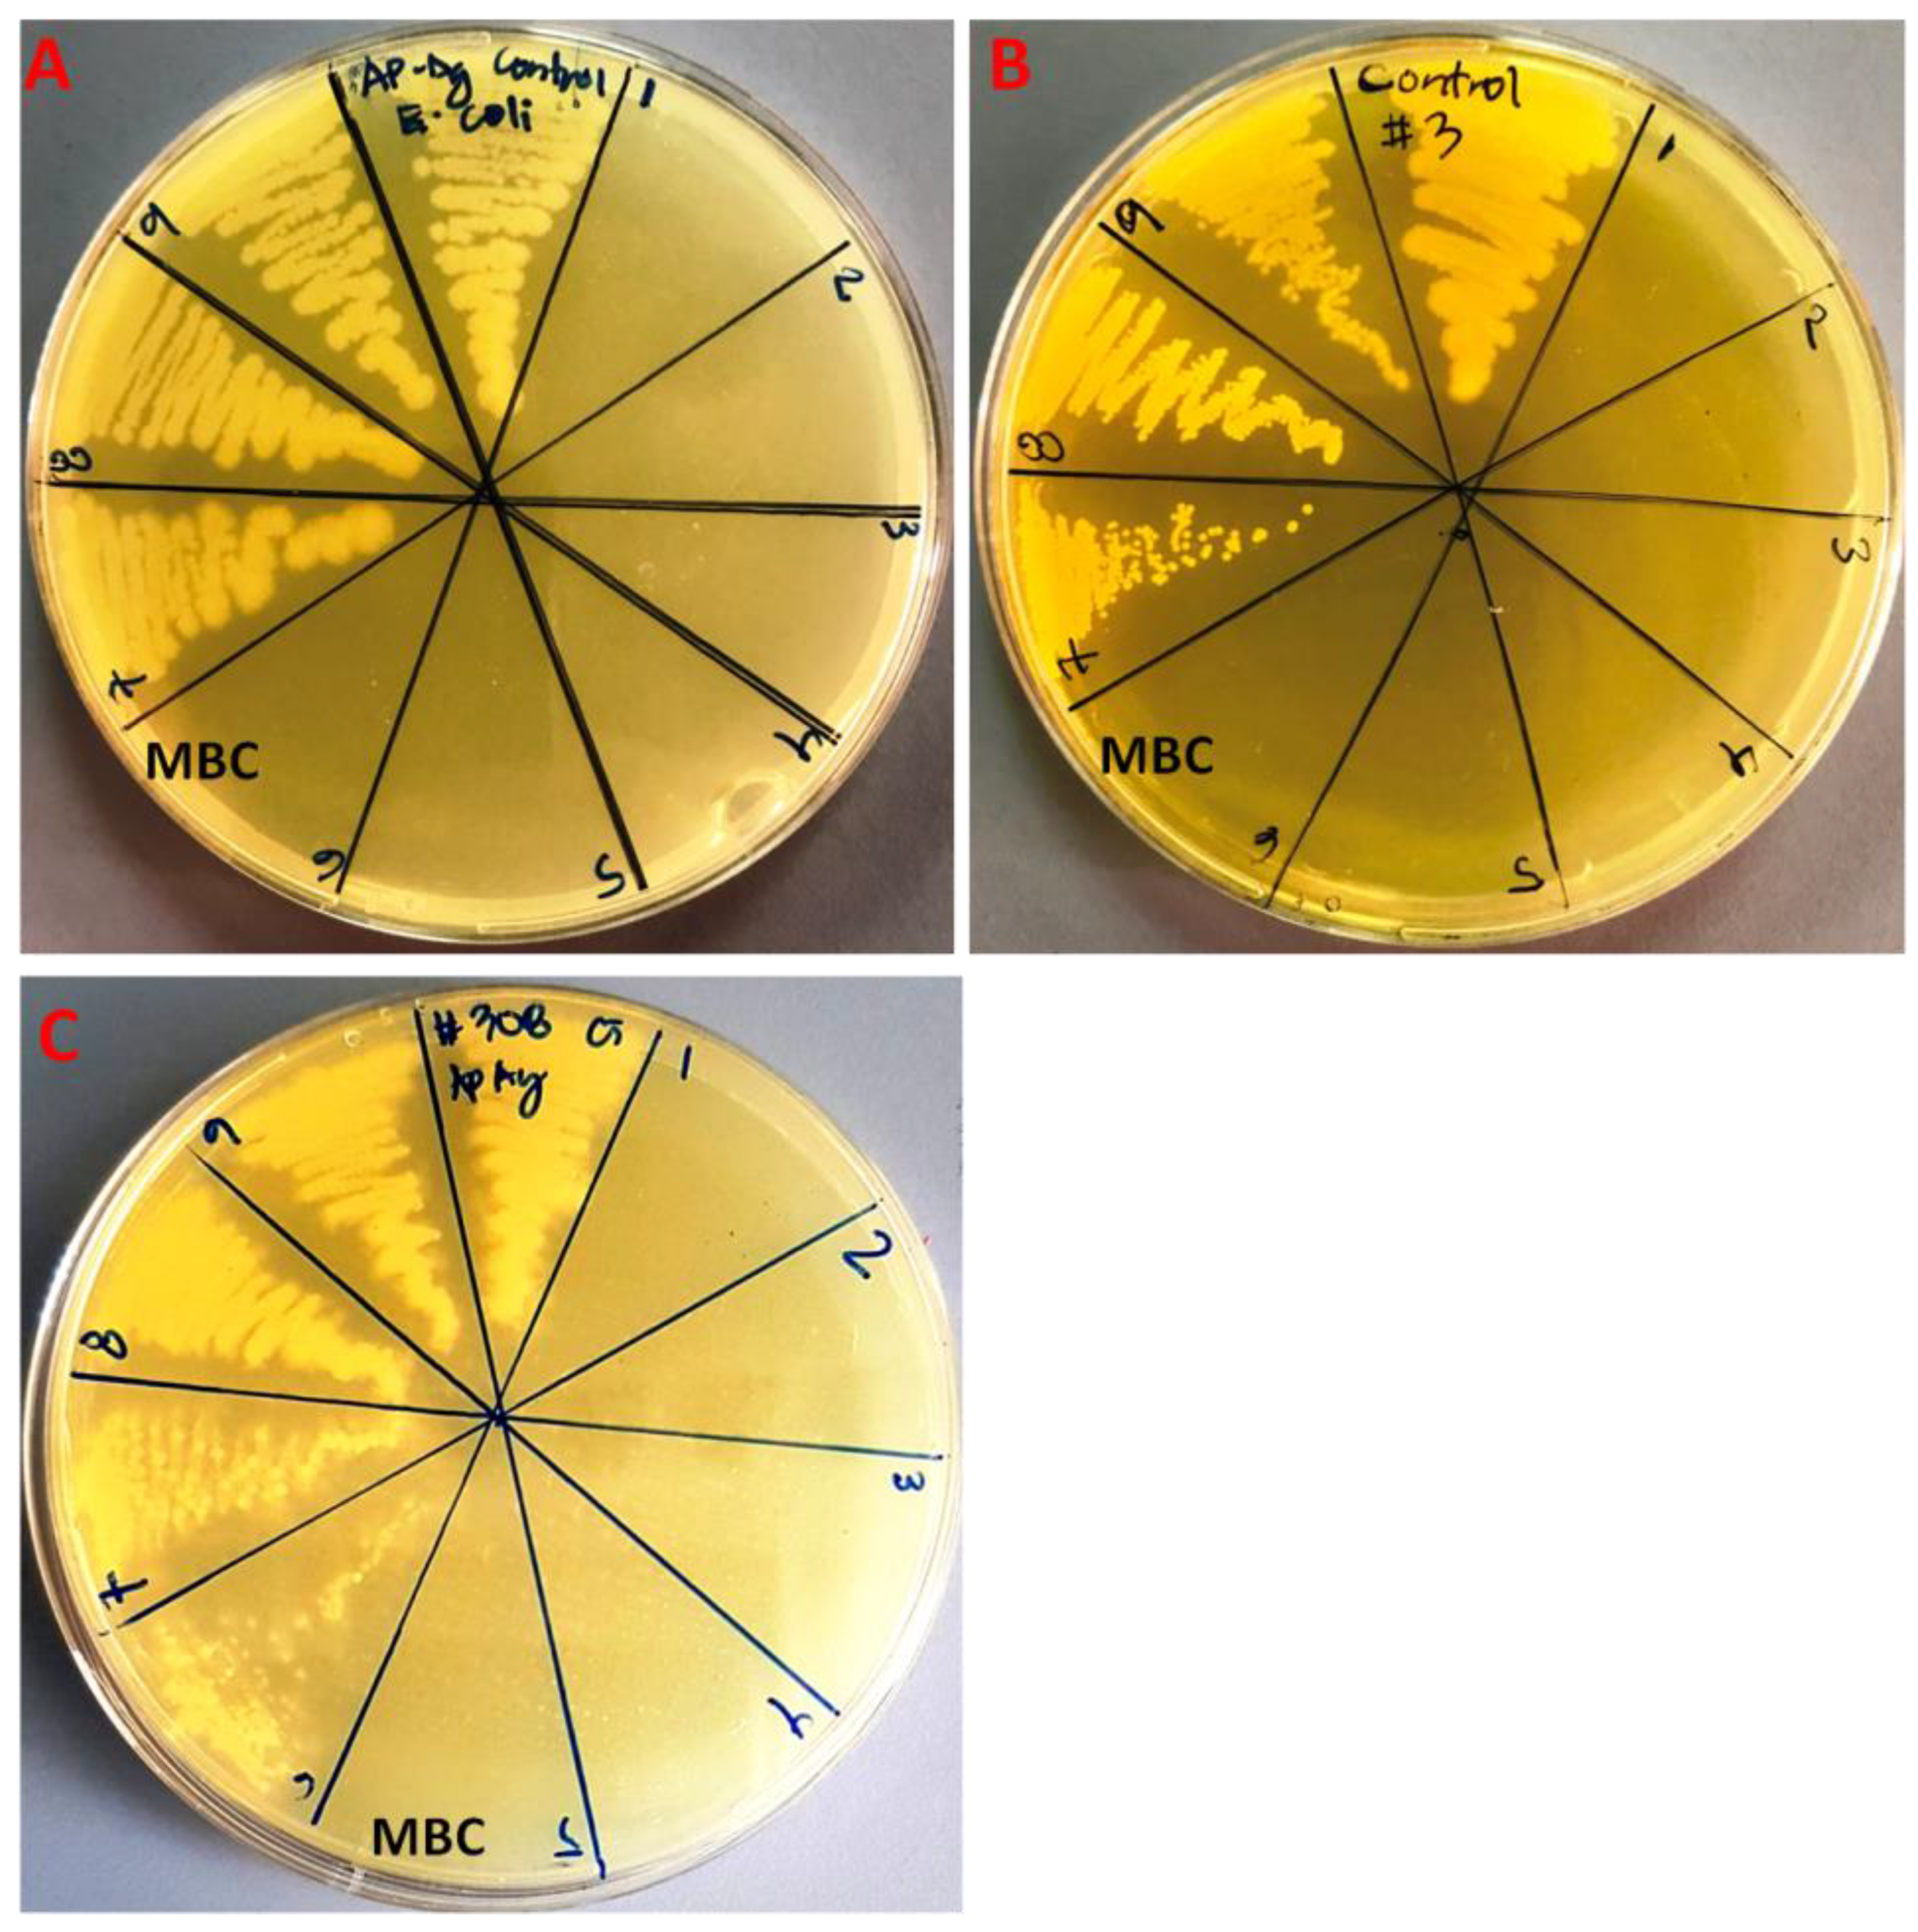
Molecules 28 00246 g006
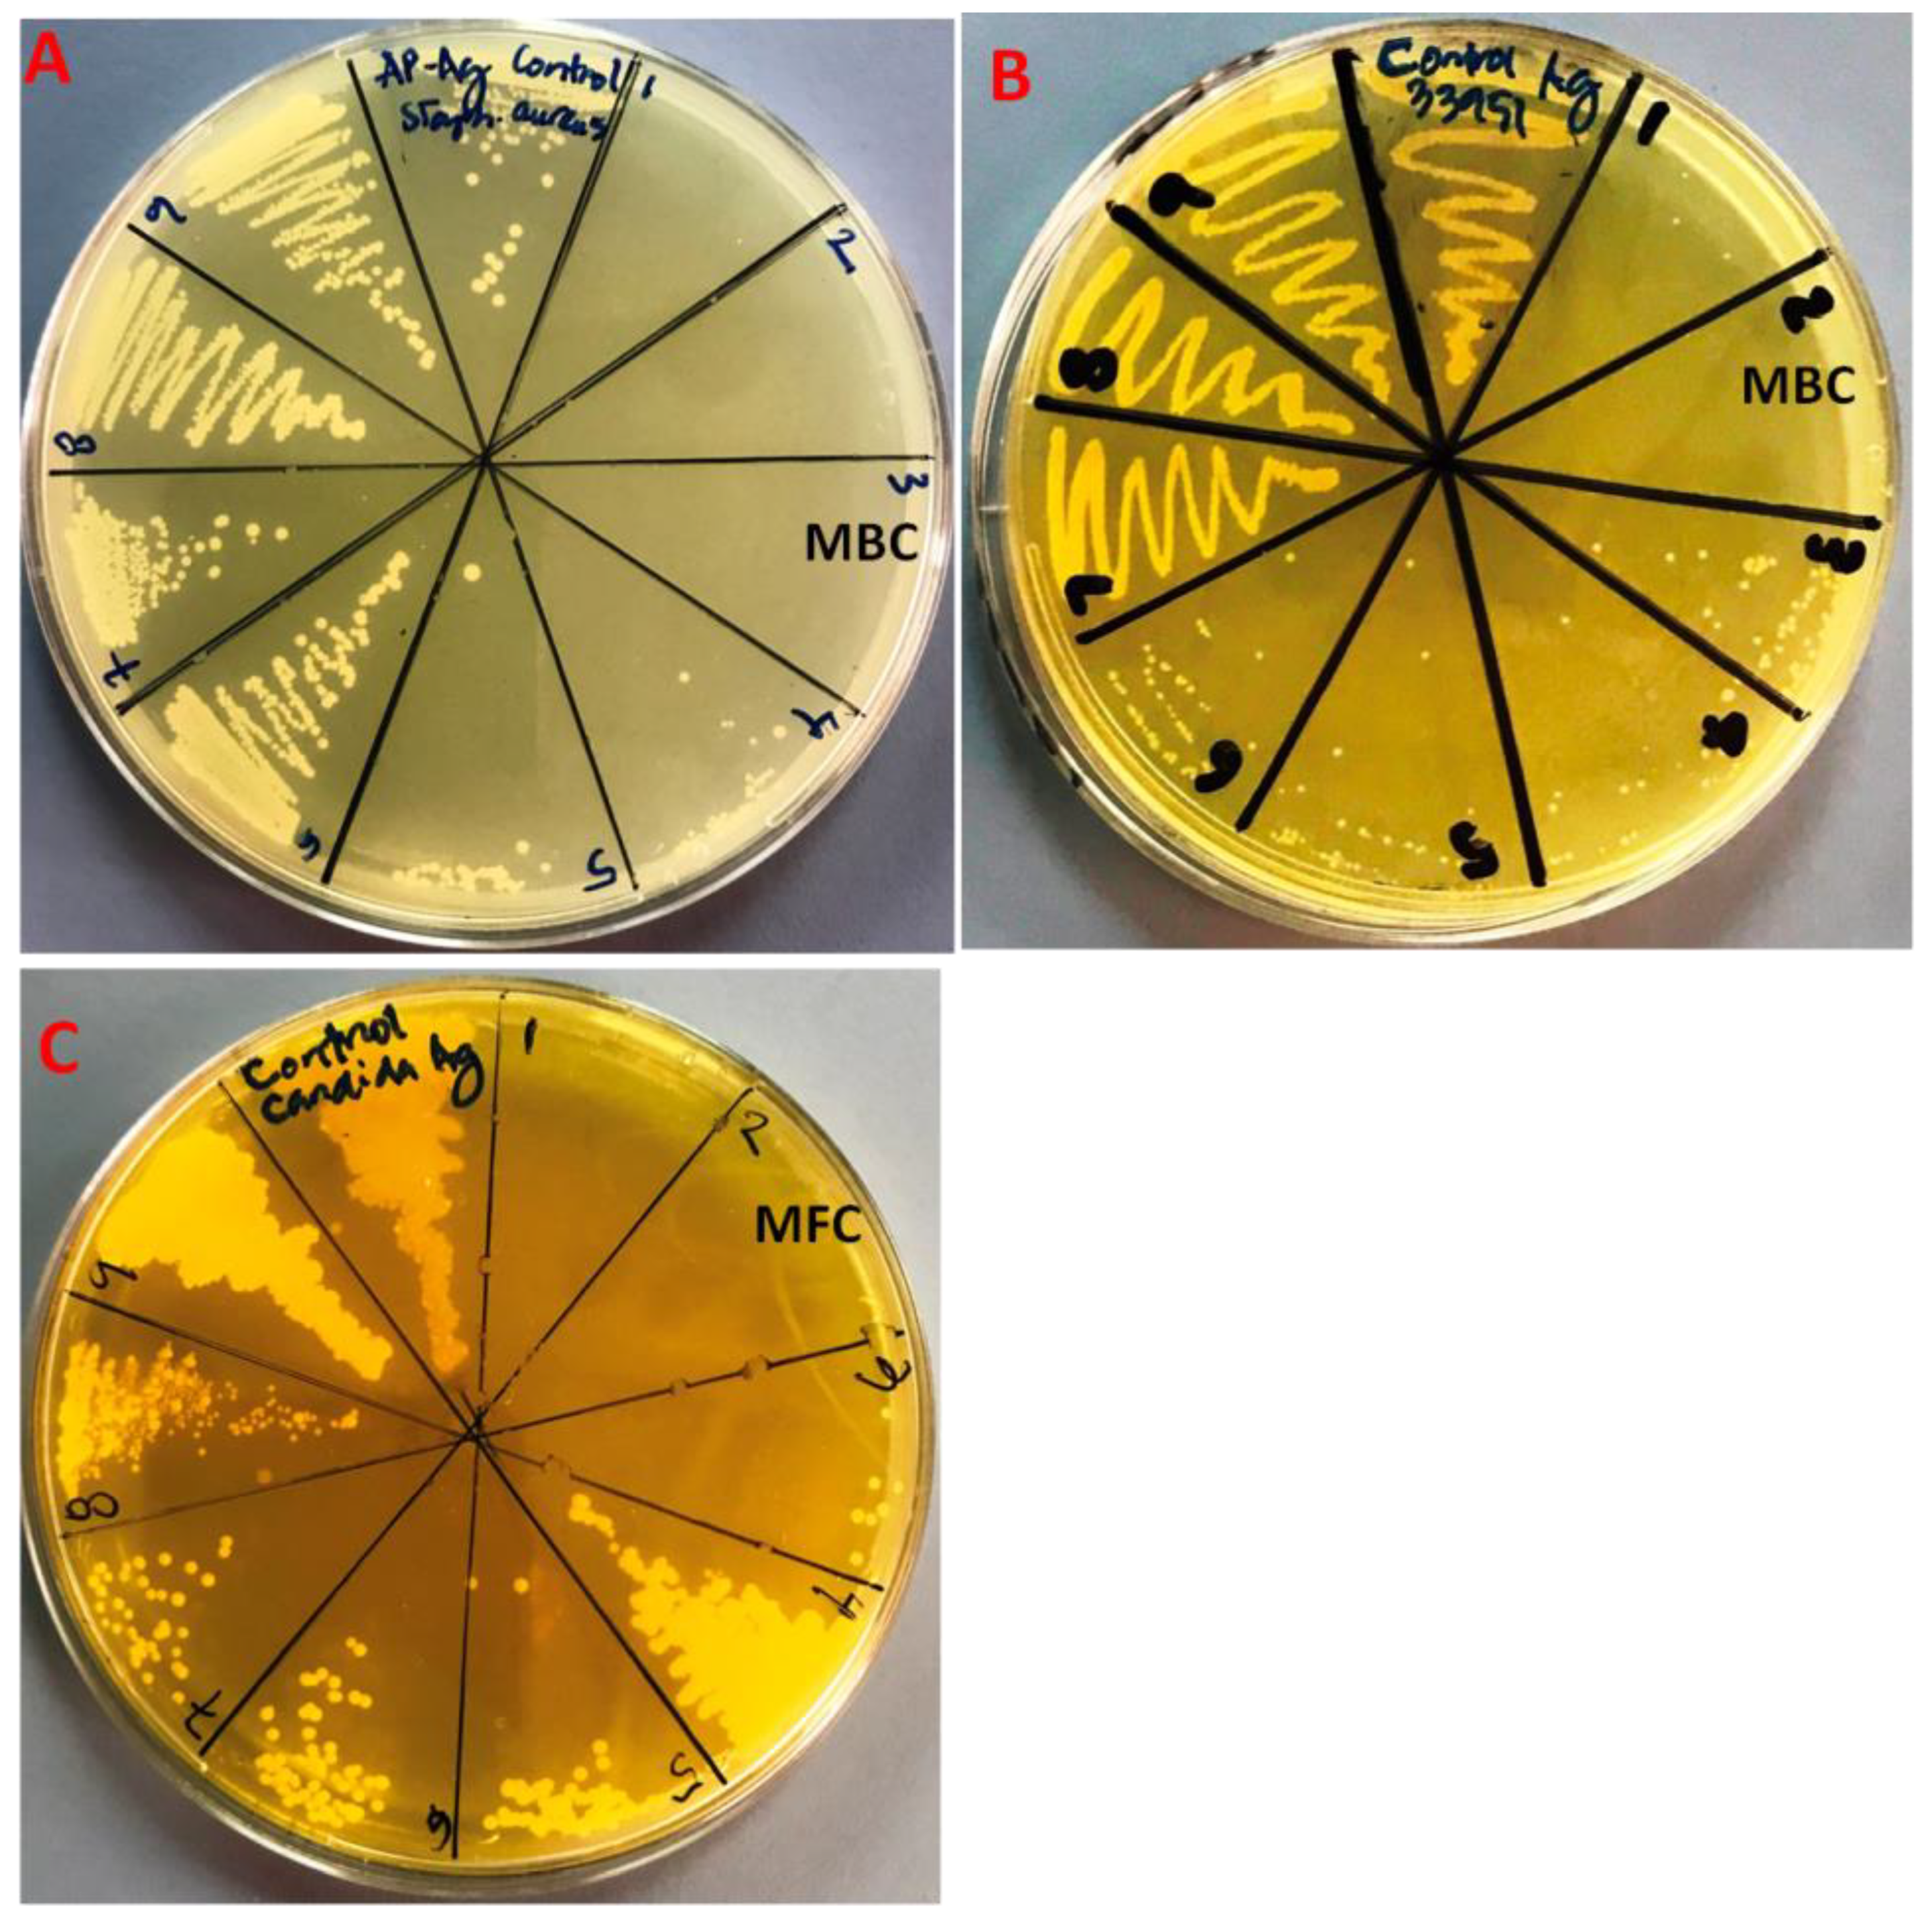
Molecules 28 00246 g007

Green Synthesis of Silver Nanoparticles Using Aerial Part Extract of the Anthemis pseudocotula Boiss. Plant and Their Biological Activity
Abstract
1. Introduction
2. Results and Discussions
2.1. UV-Vis Analysis
2.2. XRD Analysis
2.3. FT-IR Analysis
2.4. SEM and EDX Analysis
2.5. TEM Analysis
2.6. Antimicrobial Activity of AP-AgNPs
2.7. Effects of AP-AgNPs on Biofilm Formation
3. Materials and Methods
3.1. Materials
3.2. Methods
3.2.1. Preparation of Aerial Part Extract of A. pseudocotula Boiss. Plant
3.2.2. Green Synthesis of Silver Nanoparticles Using Aerial Part Extract of A. pseudocotula Boiss. Plant (AP-AgNPs)
3.3. Characterization
3.4. Strains and Media
3.5. Assessment of Antimicrobial Efficacy of AgNPs
3.5.1. Minimal Inhibitory Concentration (MIC), Minimal Bactericidal Concentration (MBC) and Minimal Fungicidal Concentration (MFC) Determination
3.5.2. Inhibition of Biofilm Formation by AgNPs
3.6. Statistical Analysis
4. Conclusions
Author Contributions
Funding
Institutional Review Board Statement
Informed Consent Statement
Data Availability Statement
Conflicts of Interest
References
- Ibrahim, R.K.; Hayyan, M.; AlSaadi, M.A.; Hayyan, A.; Ibrahim, S. Environmental application of nanotechnology: Air, soil, and water. Environ. Sci. Pollut. Res. 2016, 23, 13754–13788. [Google Scholar]
- Mauter, M.S.; Zucker, I.; Perreault, F.; Werber, J.R.; Kim, J.-H.; Elimelech, M. The role of nanotechnology in tackling global water challenges. Nat. Sustain. 2018, 1, 166–175. [Google Scholar] [CrossRef]
- Zhang, Y.-X.; Wang, Y.-H. Nonlinear optical properties of metal nanoparticles: A review. RSC Adv. 2017, 7, 45129–45144. [Google Scholar] [CrossRef]
- Hasan, S. A review on nanoparticles: Their synthesis and types. Res. J. Recent Sci. 2015, 2277, 2502. [Google Scholar]
- Hao, E.; Schatz, G.C.; Hupp, J.T. Synthesis and optical properties of anisotropic metal nanoparticles. J. Fluoresc. 2004, 14, 331–341. [Google Scholar] [CrossRef] [PubMed]
- Rao, P.V.; Nallappan, D.; Madhavi, K.; Rahman, S.; Jun Wei, L.; Gan, S.H. Phytochemicals and biogenic metallic nanoparticles as anticancer agents. Oxidative Med. Cell. Longev. 2016, 2016, 3685671. [Google Scholar] [CrossRef]
- Zayed, M.F.; Mahfoze, R.A.; El-kousy, S.M.; Al-Ashkar, E.A. In-vitro antioxidant and antimicrobial activities of metal nanoparticles biosynthesized using optimized Pimpinella anisum extract. Colloids Surf. A Physicochem. Eng. Asp. 2020, 585, 124167. [Google Scholar] [CrossRef]
- Rai, M.; Ingle, A.P.; Birla, S.; Yadav, A.; Santos, C.A.D. Strategic role of selected noble metal nanoparticles in medicine. Crit. Rev. Microbiol. 2016, 42, 696–719. [Google Scholar] [CrossRef]
- Vlamidis, Y.; Voliani, V. Bringing again noble metal nanoparticles to the forefront of cancer therapy. Front. Bioeng. Biotechnol. 2018, 6, 143. [Google Scholar] [CrossRef]
- Azharuddin, M.; Zhu, G.H.; Das, D.; Ozgur, E.; Uzun, L.; Turner, A.P.; Patra, H.K. A repertoire of biomedical applications of noble metal nanoparticles. Chem. Commun. 2019, 55, 6964–6996. [Google Scholar] [CrossRef]
- Ebrahiminezhad, A.; Zare-Hoseinabadi, A.; Sarmah, A.K.; Taghizadeh, S.; Ghasemi, Y.; Berenjian, A. Plant-mediated synthesis and applications of iron nanoparticles. Mol. Biotechnol. 2018, 60, 154–168. [Google Scholar] [CrossRef] [PubMed]
- Subhapriya, S.; Gomathipriya, P. Green synthesis of titanium dioxide (TiO2) nanoparticles by Trigonella foenum-graecum extract and its antimicrobial properties. Microb. Pathog. 2018, 116, 215–220. [Google Scholar] [CrossRef] [PubMed]
- Khan, M.; Al-Hamoud, K.; Liaqat, Z.; Shaik, M.R.; Adil, S.F.; Kuniyil, M.; Alkhathlan, H.Z.; Al-Warthan, A.; Siddiqui, M.R.H.; Mondeshki, M. Synthesis of Au, Ag, and Au–Ag bimetallic nanoparticles using Pulicaria undulata extract and their catalytic activity for the reduction of 4-nitrophenol. Nanomaterials 2020, 10, 1885. [Google Scholar] [CrossRef] [PubMed]
- Amatya, S.P.; Joshi, L.P. Bio-Synthesis of copper nanoparticles (CuNPs) using Garlic extract to investigate antibacterial activity. BIBECHANA 2020, 17, 13–19. [Google Scholar] [CrossRef]
- Khan, M.; Khan, S.T.; Khan, M.; Adil, S.F.; Musarrat, J.; Al-Khedhairy, A.A.; Al-Warthan, A.; Siddiqui, M.; Alkhathlan, H.Z. Antibacterial properties of silver nanoparticles synthesized using Pulicaria glutinosa plant extract as a green bioreductant. Int. J. Nanomed. 2014, 9, 3551–3565. [Google Scholar]
- Ansari, M.A.; Alzohairy, M.A. One-pot facile green synthesis of silver nanoparticles using seed extract of Phoenix dactylifera and their bactericidal potential against MRSA. Evid.-Based Complement. Altern. Med. 2018, 2018, 1860280. [Google Scholar] [CrossRef]
- Pauzi, N.; Zain, N.M.; Yusof, N.A.A. Gum arabic as natural stabilizing agent in green synthesis of ZnO nanofluids for antibacterial application. J. Environ. Chem. Eng. 2020, 8, 103331. [Google Scholar] [CrossRef]
- Hernández-Morales, L.; Espinoza-Gómez, H.; Flores-López, L.Z.; Sotelo-Barrera, E.L.; Núñez-Rivera, A.; Cadena-Nava, R.D.; Alonso-Núñez, G.; Espinoza, K.A. Study of the green synthesis of silver nanoparticles using a natural extract of dark or white Salvia hispanica L. seeds and their antibacterial application. Appl. Surf. Sci. 2019, 489, 952–961. [Google Scholar] [CrossRef]
- Bayrami, A.; Ghorbani, E.; Pouran, S.R.; Habibi-Yangjeh, A.; Khataee, A.; Bayrami, M. Enriched zinc oxide nanoparticles by Nasturtium officinale leaf extract: Joint ultrasound-microwave-facilitated synthesis, characterization, and implementation for diabetes control and bacterial inhibition. Ultrason. Sonochemistry 2019, 58, 104613. [Google Scholar] [CrossRef]
- Khan, M.; Shaik, M.R.; Adil, S.F.; Khan, S.T.; Al-Warthan, A.; Siddiqui, M.R.H.; Tahir, M.N.; Tremel, W. Plant extracts as green reductants for the synthesis of silver nanoparticles: Lessons from chemical synthesis. Dalton Trans. 2018, 47, 11988–12010. [Google Scholar] [CrossRef]
- Latif, M.; Abbas, S.; Kormin, F.; Mustafa, M. Green synthesis of plant-mediated metal nanoparticles: The role of polyphenols. Asian J. Pharmaceut. Clin. Res. 2019, 12, 75–84. [Google Scholar] [CrossRef]
- Shaik, M.R.; Khan, M.; Kuniyil, M.; Al-Warthan, A.; Alkhathlan, H.Z.; Siddiqui, M.R.H.; Shaik, J.P.; Ahamed, A.; Mahmood, A.; Khan, M. Plant-extract-assisted green synthesis of silver nanoparticles using Origanum vulgare L. extract and their microbicidal activities. Sustainability 2018, 10, 913. [Google Scholar] [CrossRef]
- Khan, M.; Al-Marri, A.H.; Khan, M.; Mohri, N.; Adil, S.F.; Al-Warthan, A.; Siddiqui, M.R.H.; Alkhathlan, H.Z.; Berger, R.; Tremel, W. Pulicaria glutinosa plant extract: A green and eco-friendly reducing agent for the preparation of highly reduced graphene oxide. RSC Adv. 2014, 4, 24119–24125. [Google Scholar] [CrossRef]
- Dayakar, T.; Rao, K.V.; Park, J.; Sadasivuni, K.K.; Rao, K.R. Non-enzymatic biosensing of glucose based on silver nanoparticles synthesized from Ocimum tenuiflorum leaf extract and silver nitrate. Mater. Chem. Phys. 2018, 216, 502–507. [Google Scholar] [CrossRef]
- Sampath, G.; Govarthanan, M.; Rameshkumar, N.; Vo, D.-V.N.; Krishnan, M.; Sivasankar, P.; Kayalvizhi, N. Eco-friendly biosynthesis metallic silver nanoparticles using Aegle marmelos (Indian bael) and its clinical and environmental applications. Appl. Nanosci. 2021, 1–12. [Google Scholar] [CrossRef]
- Nejadhabibvash, F. Phytochemical Composition of the Essential Oil of Anthemis Wiedemanniana Fisch. and CA Mey.(Asteraceae) from Iran during Different Growth Stages. J. Essent. Oil Bear. Plants 2017, 20, 1349–1359. [Google Scholar] [CrossRef]
- Rasheed, T.; Bilal, M.; Iqbal, H.M.; Li, C. Green biosynthesis of silver nanoparticles using leaves extract of Artemisia vulgaris and their potential biomedical applications. Colloids Surf. B Biointerfaces 2017, 158, 408–415. [Google Scholar] [CrossRef]
- Khatoon, N.; Mazumder, J.A.; Sardar, M. Biotechnological applications of green synthesized silver nanoparticles. J. Nanosci. Curr. Res. 2017, 2, 107. [Google Scholar] [CrossRef]
- Francis, S.; Joseph, S.; Koshy, E.P.; Mathew, B. Green synthesis and characterization of gold and silver nanoparticles using Mussaenda glabrata leaf extract and their environmental applications to dye degradation. Environ. Sci. Pollut. Res. 2017, 24, 17347–17357. [Google Scholar] [CrossRef]
- Patil, K.B.; Patil, N.B.; Patil, S.V.; Patil, V.K.; Shirsath, P.C. Metal based Nanomaterial’s (Silver and Gold): Synthesis and Biomedical application. Asian J. Pharm. Technol. 2020, 10, 97–106. [Google Scholar] [CrossRef]
- Some, S.; Sen, I.K.; Mandal, A.; Aslan, T.; Ustun, Y.; Yilmaz, E.Ş.; Katı, A.; Demirbas, A.; Mandal, A.K.; Ocsoy, I. Biosynthesis of silver nanoparticles and their versatile antimicrobial properties. Mater. Res. Express 2018, 6, 012001. [Google Scholar] [CrossRef]
- Smitha, S.; Nissamudeen, K.; Philip, D.; Gopchandran, K. Studies on surface plasmon resonance and photoluminescence of silver nanoparticles. Spectrochim. Acta Part A Mol. Biomol. Spectrosc. 2008, 71, 186–190. [Google Scholar] [CrossRef] [PubMed]
- Khan, M.; Khan, M.; Adil, S.F.; Tahir, M.N.; Tremel, W.; Alkhathlan, H.Z.; Al-Warthan, A.; Siddiqui, M.R.H. Green synthesis of silver nanoparticles mediated by Pulicaria glutinosa extract. Int. J. Nanomed. 2013, 8, 1507. [Google Scholar]
- Kanniah, P.; Radhamani, J.; Chelliah, P.; Muthusamy, N.; Joshua Jebasingh Sathiya Balasingh Thangapandi, E.; Reeta Thangapandi, J.; Balakrishnan, S.; Shanmugam, R. Green synthesis of multifaceted silver nanoparticles using the flower extract of Aerva lanata and evaluation of its biological and environmental applications. ChemistrySelect 2020, 5, 2322–2331. [Google Scholar] [CrossRef]
- Ansari, M.A.; Asiri, S.M.M.; Alzohairy, M.A.; Alomary, M.N.; Almatroudi, A.; Khan, F.A. Biofabricated Fatty Acids-Capped Silver Nanoparticles as Potential Antibacterial, Antifungal, Antibiofilm and Anticancer Agents. Pharmaceuticals 2021, 14, 139. [Google Scholar] [CrossRef]
- Alqahtani, M.A.; Al Othman, M.R.; Mohammed, A.E. Bio fabrication of silver nanoparticles with antibacterial and cytotoxic abilities using lichens. Sci. Rep. 2020, 10, 16781. [Google Scholar] [CrossRef] [PubMed]
- Mohanbaba, S.; Gurunathan, S. Differential biological activities of silver nanoparticles against Gram-negative and Gram-positive bacteria: A novel approach for antimicrobial therapy. In Nanobiomaterials in Antimicrobial Therapy; Elsevier: Amsterdam, The Netherlands, 2016; pp. 193–227. [Google Scholar]
- Jung, W.K.; Koo, H.C.; Kim, K.W.; Shin, S.; Kim, S.H.; Park, Y.H. Antibacterial activity and mechanism of action of the silver ion in Staphylococcus aureus and Escherichia coli. Appl. Environ. Microbiol. 2008, 74, 2171–2178. [Google Scholar] [CrossRef]
- Rajeshkumar, S.; Bharath, L. Mechanism of plant-mediated synthesis of silver nanoparticles–a review on biomolecules involved, characterisation and antibacterial activity. Chem.-Biol. Interact. 2017, 273, 219–227. [Google Scholar] [CrossRef]
- Pal, S.; Tak, Y.K.; Song, J.M. Does the antibacterial activity of silver nanoparticles depend on the shape of the nanoparticle? A study of the gram-negative bacterium Escherichia coli. Appl. Environ. Microbiol. 2007, 73, 1712–1720. [Google Scholar] [CrossRef]
- Ansari, M.A.; Kalam, A.; Al-Sehemi, A.G.; Alomary, M.N.; AlYahya, S.; Aziz, M.K.; Srivastava, S.; Alghamdi, S.; Akhtar, S.; Almalki, H.D. Counteraction of biofilm formation and antimicrobial potential of Terminalia catappa functionalized silver nanoparticles against Candida albicans and multidrug-resistant Gram-negative and Gram-positive bacteria. Antibiotics 2021, 10, 725. [Google Scholar] [CrossRef]
- Allemailem, K.S.; Khadri, H.; Azam, M.; Khan, M.A.; Rahmani, A.H.; Alrumaihi, F.; Khateef, R.; Ansari, M.A.; Alatawi, E.A.; Alsugoor, M.H. Ajwa-Dates (Phoenix dactylifera)-Mediated Synthesis of Silver Nanoparticles and Their Anti-Bacterial, Anti-Biofilm, and Cytotoxic Potential. Appl. Sci. 2022, 12, 4537. [Google Scholar] [CrossRef]
- Elsharif, A.M.; Youssef, T.E.; Al-Jameel, S.S.; Mohamed, H.H.; Ansari, M.A.; Rehman, S.; Akhtar, S. Synthesis of an activatable tetra-substituted nickel phthalocyanines-4 (3H)-quinazolinone conjugate and its antibacterial activity. Adv. Pharmacol. Sci. 2019, 2019, 5964687. [Google Scholar] [CrossRef] [PubMed]
- Ansari, M.A.; Asiri, S.M.M. Green synthesis, antimicrobial, antibiofilm and antitumor activities of superparamagnetic γ-Fe2O3 NPs and their molecular docking study with cell wall mannoproteins and peptidoglycan. Int. J. Biol. Macromol. 2021, 171, 44–58. [Google Scholar] [CrossRef] [PubMed]
- Alomary, M.N.; Ansari, M.A. Proanthocyanin-Capped Biogenic TiO2 Nanoparticles with Enhanced Penetration, Antibacterial and ROS Mediated Inhibition of Bacteria Proliferation and Biofilm Formation: A Comparative Approach. Chem. A Eur. J. 2021, 27, 5817–5829. [Google Scholar] [CrossRef]
- Baig, U.; Gondal, M.; Ansari, M.; Dastageer, M.; Sajid, M.; Falath, W. Rapid synthesis and characterization of advanced ceramic-polymeric nanocomposites for efficient photocatalytic decontamination of hazardous organic pollutant under visible light and inhibition of microbial biofilm. Ceram. Int. 2021, 47, 4737–4748. [Google Scholar] [CrossRef]

| 2θ (°) | d Space (nm) | (h, k, l) | a (nm) | Crystallite Size, D (nm) |
|---|---|---|---|---|
| 37.9 | 0.24 | 111 | 0.41 | 7.96 |
| 46.0 | 0.20 | 200 | 11.64 | |
| 64.2 | 0.14 | 220 | 8.68 | |
| 77.0 | 0.12 | 311 | 7.01 | |
| 81.3 | 0.12 | 222 | 10.52 |
| Strains | MIC (mg/mL) | MBC (mg/mL) |
|---|---|---|
| MDR-P. aeruginosa | 0.039 | 0.156 |
| E. coli ATCC 25922 | 0.078 | 0.156 |
| MDR-A. baumannii | 0.078 | 0.312 |
| MRSA ATCC 33593 | 0.625 | 2.5 |
| S. aureus ATCC 22923 | 0.312 | 1.25 |
| C. albicans ATCC 14053 | 0.625 | 2.5 |
Disclaimer/Publisher’s Note: The statements, opinions and data contained in all publications are solely those of the individual author(s) and contributor(s) and not of MDPI and/or the editor(s). MDPI and/or the editor(s) disclaim responsibility for any injury to people or property resulting from any ideas, methods, instructions or products referred to in the content. |
© 2022 by the authors. Licensee MDPI, Basel, Switzerland. This article is an open access article distributed under the terms and conditions of the Creative Commons Attribution (CC BY) license (https://creativecommons.org/licenses/by/4.0/).
Share and Cite
Ajlouni, A.-W.; Hamdan, E.H.; Alshalawi, R.A.E.; Shaik, M.R.; Khan, M.; Kuniyil, M.; Alwarthan, A.; Ansari, M.A.; Khan, M.; Alkhathlan, H.Z.; et al. Green Synthesis of Silver Nanoparticles Using Aerial Part Extract of the Anthemis pseudocotula Boiss. Plant and Their Biological Activity. Molecules 2023, 28, 246. https://doi.org/10.3390/molecules28010246
Ajlouni A-W, Hamdan EH, Alshalawi RAE, Shaik MR, Khan M, Kuniyil M, Alwarthan A, Ansari MA, Khan M, Alkhathlan HZ, et al. Green Synthesis of Silver Nanoparticles Using Aerial Part Extract of the Anthemis pseudocotula Boiss. Plant and Their Biological Activity. Molecules. 2023; 28(1):246. https://doi.org/10.3390/molecules28010246
Chicago/Turabian StyleAjlouni, Abdul-Wali, Eman H. Hamdan, Rasha Awwadh Eid Alshalawi, Mohammed Rafi Shaik, Mujeeb Khan, Mufsir Kuniyil, Abdulrahman Alwarthan, Mohammad Azam Ansari, Merajuddin Khan, Hamad Z. Alkhathlan, and et al. 2023. "Green Synthesis of Silver Nanoparticles Using Aerial Part Extract of the Anthemis pseudocotula Boiss. Plant and Their Biological Activity" Molecules 28, no. 1: 246. https://doi.org/10.3390/molecules28010246
APA StyleAjlouni, A.-W., Hamdan, E. H., Alshalawi, R. A. E., Shaik, M. R., Khan, M., Kuniyil, M., Alwarthan, A., Ansari, M. A., Khan, M., Alkhathlan, H. Z., Shaik, J. P., & Adil, S. F. (2023). Green Synthesis of Silver Nanoparticles Using Aerial Part Extract of the Anthemis pseudocotula Boiss. Plant and Their Biological Activity. Molecules, 28(1), 246. https://doi.org/10.3390/molecules28010246

